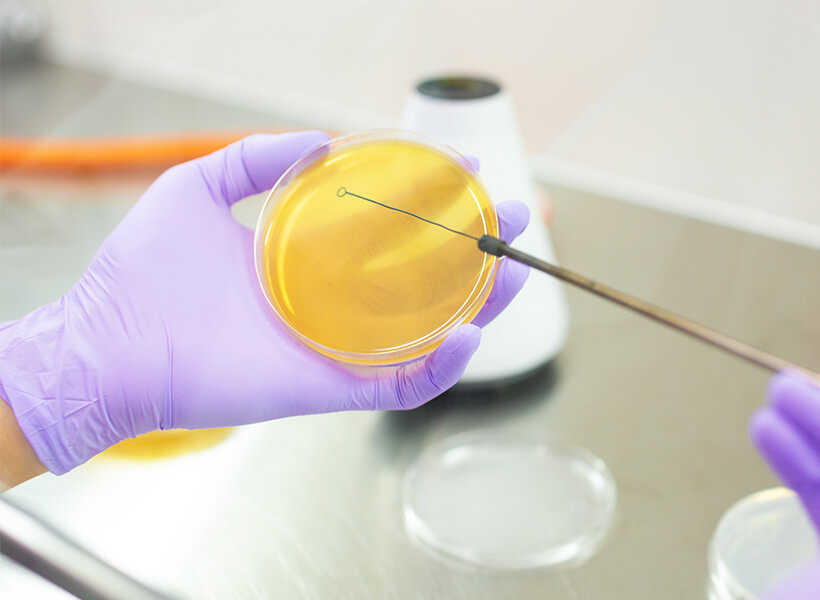

研究设施介绍
研究设施“雾岛生物技术实验室”


通过充实各种实验环境和实验设备来致力于研究开发。

产品开发室
以工厂万分之一的规模进行烧酒和烈酒的酿造试验。配备了用于评估试制品的分析设备。这正是产品开发的起点。

GC/LC分析室
利用各种设备进行与产品开发相关的成分分析。
根据获得的数据设计和控制产品的“风味”,在此方面发挥着重要作用。
微生物培养室
对烧酒酿造所必需的曲菌和酵母菌进行管理、培养和育种。
这些微生物是酿造各种烧酒的基础。

基因解析室
鉴定新的曲菌和酵母菌,并解析影响烧酒风味的基因。
正在探索微生物所拥有的全新可能。

功能探索室
从烧酒酿造和产品开发中产生的各种原料中提取、分离和纯化功能成分。正在向未知成分的探索发起挑战。



